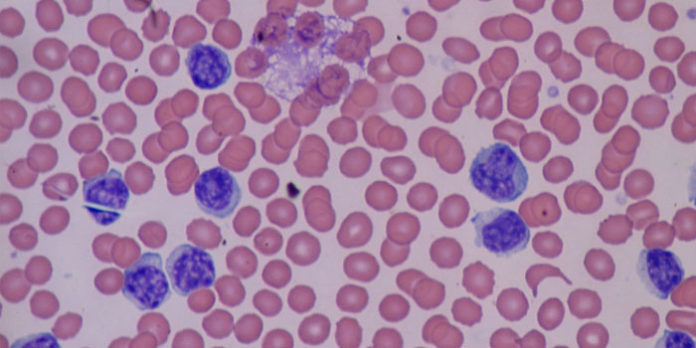

Basofilia se refiere a cuando hay demasiados basófilos en la sangre de una persona. Los basófilos son un tipo de glóbulo blanco. La basofilia no es una condición en sí misma, pero puede ser un marcador importante de otros problemas médicos subyacentes.
¿Qué es basofilia?
La basofilia generalmente indica la existencia de otra afección médica subyacente.
En individuos sanos, los basófilos representan una cantidad mínima de la población de células del cuerpo. Sin embargo, las personas con basofilia tienen una cantidad anormalmente alta de basófilos.
Los basófilos son un tipo de glóbulo blanco producido en la médula ósea. Los glóbulos blancos ayudan al cuerpo a combatir las infecciones.
Un alto nivel de glóbulos blancos puede indicar una respuesta inmune en el cuerpo, que protege al cuerpo de infecciones y otros problemas. Sin embargo, cuando una persona tiene basofilia, el aumento de glóbulos blancos puede deberse a causas más graves.
La basofilia rara vez existe de manera independiente y con mayor frecuencia indica la presencia de otra afección.
Causas y factores de riesgo
Las causas más comunes de basofilia incluyen:
- infecciones
- alergias
- trastornos y enfermedades caracterizados por inflamación crónica
- trastornos mieloproliferativos
Infecciones
Las infecciones a menudo desencadenan una respuesta inflamatoria en el cuerpo, que puede hacer que una persona tenga más probabilidades de desarrollar basofilia.
Sin embargo, el desarrollo de basofilia como resultado de una infección o enfermedad aguda es raro. Ciertas enfermedades, como la varicela y la tuberculosis, pueden hacer que una persona tenga más probabilidades de desarrollar basofilia.
Alergias
Las alergias y las reacciones alérgicas a los alimentos y las drogas pueden causar basofilia. La gravedad de la alergia o la respuesta pueden correlacionarse con la gravedad de la basofilia.
Inflamación crónica
Muchos trastornos y enfermedades están directamente relacionados con la inflamación crónica. Una persona con una afección caracterizada por inflamación puede tener más probabilidades de desarrollar basofilia.
Las condiciones que causan inflamación crónica incluyen:
- Artritis Reumatoide
- enfermedad inflamatoria intestinal (EII)
- psoriasis
- tiroiditis de Hashimoto
Trastornos mieloproliferativos
Los trastornos mieloproliferativos hacen que la médula ósea produzca en exceso diferentes tipos de células sanguíneas, incluidos los basófilos.
Los trastornos mieloproliferativos que pueden causar basofilia incluyen los siguientes:
- trombocitemia esencial
- leucemia mielógena crónica
- policitemia vera
- mielofibrosis primaria
- mastocitosis sistémica
- síndrome hipereosinofílico
Síntomas
Los síntomas de la basofilia varían, pero pueden incluir fatiga, dolor abdominal y calambres.
Una cantidad anormalmente alta de basófilos puede causar una variedad de síntomas inespecíficos.
Basofilia puede causar:
- dolor abdominal y calambres
- pérdida de peso inexplicable
- fatiga
- fiebre
- malestar o sentimientos generales de malestar
Sin embargo, los síntomas que experimenta una persona con basofilia varían según su afección médica subyacente.
Las personas que tienen basofilia debido a una infección tendrán síntomas de la infección, que pueden incluir fiebre, fatiga y malestar general.
Una persona con basofilia como resultado de alergias tendrá síntomas de alergia típicos, que incluyen:
- estornudando
- nariz congestionada
- ojos que pican
- sarpullido o urticaria
- sibilancias
- hinchazón
Una persona que tiene basofilia como resultado de IBD puede experimentar:
- Calambre abdominal
- Diarrea
- sangrado por el recto
- dolor en el área rectal
La basofilia causada por una afección que causa inflamación crónica puede causar síntomas como:
- fatiga
- dolores y dolores musculares
- hinchazón
- fiebre leve
- entumecimiento y hormigueo en las manos y los pies
- erupciones cutáneas, en el caso de la psoriasis
Las personas con basofilia como resultado de un trastorno mieloproliferativo pueden tener diferentes síntomas según el trastorno que tengan. Los síntomas pueden incluir:
- debilidad
- dolores de cabeza
- cambios de visión
- sangrado y moretones fáciles
- dificultad para respirar
- entumecimiento u hormigueo en las manos y los pies
- dolor de huesos
Los síntomas de las causas subyacentes de la basofilia son diferentes para todos. Las personas con síntomas inexplicables que no se resuelven con el tiempo deben visitar a su médico.
Diagnóstico
Los médicos a menudo notan basofilia durante un conteo sanguíneo completo con diferencial (CBC con diferencia). Cuando el diferencial revela altos niveles de basófilos, es probable que un médico ordene más pruebas para determinar la causa.
Según los otros síntomas de la persona, estos exámenes pueden incluir una combinación de los siguientes:
- análisis de sangre
- biopsia de médula ósea
- ultrasonidos y pruebas de imagen
- Prueba genética
Complicaciones
La basofilia sola no causa complicaciones, pero las causas subyacentes de la basofilia pueden serlo. Las complicaciones varían según la causa de la basofilia y pueden ser graves.
Estos incluyen los siguientes:
- sangrado abundante
- bazo agrandado
- infecciones frecuentes
Tratamiento
Tomar antihistamínicos puede ayudar a prevenir los síntomas de la alergia.
No es probable que la basofilia sea tratada directamente. En cambio, el tratamiento se enfocará en la condición médica subyacente de la persona.
Las infecciones bacterianas que causan basofilia requerirán antibióticos. Un médico también puede recomendar descanso y abundantes líquidos.
Los tratamientos para las alergias incluyen:
- evitando el alergeno
- antihistamínicos
- crema de hidrocortisona
- corticosteroides
- epinefrina
El tratamiento de enfermedades inflamatorias, como la artritis reumatoide y la EII, puede incluir medicamentos inmunosupresores y antiinflamatorios.
El tratamiento para un trastorno mieloproliferativo es probable que sea complejo y variará dependiendo de la situación de un individuo. Puede incluir lo siguiente:
- quimioterapia
- terapia de radiación
- trasplantes de células madre
- cirugía para extirpar el bazo
Resumen
El pronóstico para las personas con basofilia varía según la causa subyacente. Las infecciones leves deben desaparecer con descanso y tratamiento.
Las enfermedades inflamatorias y las alergias a menudo son condiciones de por vida que se pueden controlar con medicamentos y cambios en el estilo de vida.
Las personas con basofilia causada por una condición grave, como un trastorno mieloproliferativo, deben desarrollar un plan de tratamiento individualizado con su médico.
basofilia, basofilia causas, que es la basofilia, basofilia difusa, basofilia citoplasmatica, basofilia difusa causas






